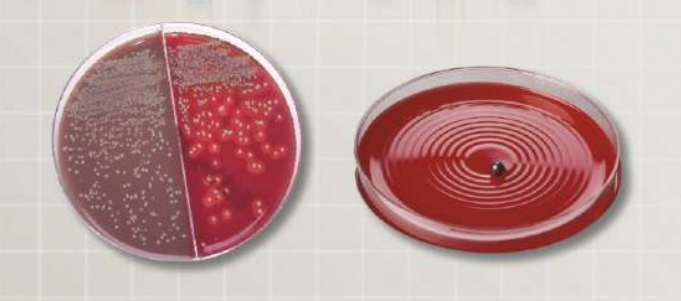

BD Kiestra™ представляет собой компактное решение для лабораторий с различными потоками, позволяющее автоматизировать обработку образцов и посев, инкубацию чашек и получение цифровых изображений результатов посева.
Посев исследуемого материала – очень ответственный и вместе с тем трудоемкий процесс. Квалификация персонала, выполняющего данную процедуру, должна быть достаточно высокой, чтобы из поступившего в лабораторию образца удалось выделить искомый возбудитель. Существующие принципы выделения чистой культуры, основанные на технике штрихового посева, посева по Дригальскому или методе серийных разведений, повышают вероятность получения отдельных колоний, но нивелировать влияние человеческого фактора не могут. И хотя прошло уже более 100 лет с того момента, когда Р. Кох впервые опубликовал работу «Методы изучения патогенных микроорганизмов», где предложил использовать плотную питательную среду для выращивания микроорганизмов, в современных бактериологических лабораториях, мало, что изменилось, а автоматизация процедуры посева так и осталась для многих бактериологов заветной мечтой. Однако в настоящее время уровень развития технологий позволяет автоматизировать самые сложные ручные процессы, в том числе и диагностические. Компания Becton Dickinson смогла наиболее полно и высокотехнологично реализовать концепцию полностью автоматизированной микробиологической лаборатории на основе уникальной мультифункциональной платформы BD Kiestra™
BD Kiestra™ InoqulA™ обеспечивает достаточное число изолированных колоний для работы с первичной чашкой в более чем 95% случаев
В системе BD Kiestra™ InoqulA™ посев выполняется магнитным крутящимся шариком: шарик крутится и бегает по агару, покрывая более 90% поверхности, разбивая конгломераты микробных клеток и равномерно распределяя материал по всей площади чашки. Уникальная технология крутящегося шарика позволяет получить в 3-5 раз больше изолированных колоний по сравнению с ручным посевом или автоматическим посевом петлей/гребенкой. BD Kiestra™ InoqulA™ – единственная система, позволяющая избежать рассевов для получения чистой культуры и связанных с этим временных, трудовых и материальных затрат, позволяющая сократить время до получения результата, в том числе для образцов с высокой степенью обсемененности. BD Kiestra™ InoqulA™ выполняет любой рисунок посева, в том числе полуколичественные посевы и посев газоном для определения чувствительности к антимикробным препаратам диско-диффузионным методом.
Работа с любыми типами образцов
BD Kiestra™ InoqulA™ автоматизирует посев жидких и нежидких образцов. Около 65% образцов в лаборатории микробиологии – нежидкие (вязкая мокрота, сухие тампоны, кал, агаризованные транспортные среды, пр.). Перевод образцов в жидкую форму путем использования жидких транспортных сред связан с дополнительными расходами: жидкие транспортные среды в 4-5 раз дороже, чем их агаризованные (нежидкие) аналоги, и в 10-15 раз дороже стерильных контейнеров и сухих тампонов. Около 10% образцов нельзя перевести в жидкую форму. InoqulA™ – единственная система, автоматизирующая посев нежидких образцов, то есть единственная система, обеспечивающая стандартизацию и высокое качество посева для 100% образцов без дополнительных затрат на жидкие транспортные среды.
Высокая скорость
BD Kiestra™ InoqulA™ – самая производительная система посева в мире. Ее производительность зависит от режима работы и протокола посева; максимальная производительность системы BD Kiestra™ InoqulA™ – 400 посевов в час. BD Kiestra™ InoqulA™ производит посев всех образцов в одной рабочей сессии, без их предварительной сортировки и без перепрограммирования сортера (сортер на 12 типов сред). BD Kiestra™ InoqulA™ автоматически открывает и закрывает контейнеры с образцами, выполняет посев на чашки (стандартные и двухсекционные) и в пробирки, а также подготовку мазков. Высокая производительность позволяет справиться с большим объемом исследований и существенно сократить трудозатраты на первичный посев (самая трудозатратная часть микробиологического исследования): требуется не более одной штатной единицы в смену для выполнения всех микробиологических посевов.
Преимущества
Посев
• система осуществляет автоматический посев как жидких, так и твердых микробиологических образцов
• жидкие образцы, такие как моча и образцы в транспортных
• системах обрабатываются в автоматическом режиме, включая открывание и закрывание контейнеров
• твердые образцы обрабатываются в модуле с ручным взаимодействием, что позволяет дополнительно увеличить производительность
• посев на чашки, в пробирки с бульонами и приготовление мазков осуществляется согласно протоколам, прописанным в лабораторной информационной системе
• система хранения чашек с питательными средами настраивается в соответствии с вашим рабочим процессом, требуемой производительностью и числом используемых типов сред
• штрих-код автоматически наклеивается на бок каждой чашки, чтобы не создавать помех цифровому учету результатов посева
Технология магнитного шарика
• для посева образца на чашки настраиваемыми схемами используется защищенная патентом технология магнитного шарика
• технология магнитного шарика позволяет получить в 3-5 раз больше изолированных колоний по сравнению с ручным посевом

Высокая скорость
• каждый посевной модуль выполняет посев на 5 чашек одновременно, что обеспечивает высокую производительность и позволяет справиться с большим объемом исследований
• общая продуктивность зависит от режима работы, протоколов посева и количества систем посева
Инкубация
• интегрированная трековая система транспортирует чашки к инкубаторам и от них
• инкубация чашек и цифровой учет результатов осуществляется непрерывно, для обеспечения круглосуточной работы лаборатории 7 дней в неделю
• каждой чашке присваивается уникальная ячейка, что обеспечивает быструю визуализацию, доставку к рабочему месту и прослеживаемость
• технология ламинарного потока позволяет создать оптимальные условия инкубации
Учет результатов посева
• врачи-бактериологи просматривают высококачественные цифровые фотографии чашек с высоким разрешением
• программные средства позволяют сортировать изображения по наличию или отсутствию роста, что упрощает и ускоряет просмотр и интерпретацию
• учет результатов можно выполнять в отдельном помещении, что обеспечивает идеальные условия для работы врачей и максимальную производительность
• цифровые изображения чашек можно сохранять и просматривать позже, что делает возможным непрерывное обучение персонала, а также обучение с помощью интернета
• концепция телебактериологии позволяет проводить анализ фотографий чашек удаленно, в том числе из ординаторской, из сателлитной лаборатории и даже из дома
Сокращение трудозатрат
• сокращение трудозатрат на первичный посев
• сокращение трудозатрат на пересев
• сокращение трудозатрат на пересмотр чашек
Перед микробиологическими лабораториями стоит множество сложных задач, в том числе постоянно возрастающий объем работы, необходимость оптимизации расходов, нехватка персонала и появление новых методов исследования. Все это приводит к потребности делать больше исследований с меньшими ресурсозатратами. Решения BD Kiestra™ созданы, чтобы помочь оперативно справиться с поставленными задачами и подготовить вашу лабораторию к будущему. Каждая лаборатория по-своему уникальна, поэтому BD Kiestra™ предлагает индивидуальный подход и широкий спектр решений по автоматизации для разнообразных нужд. Совместные решения позволят рационализировать процесс исследования, повысить эффективность лаборатории и получить еще более достоверные и быстрые результаты.








